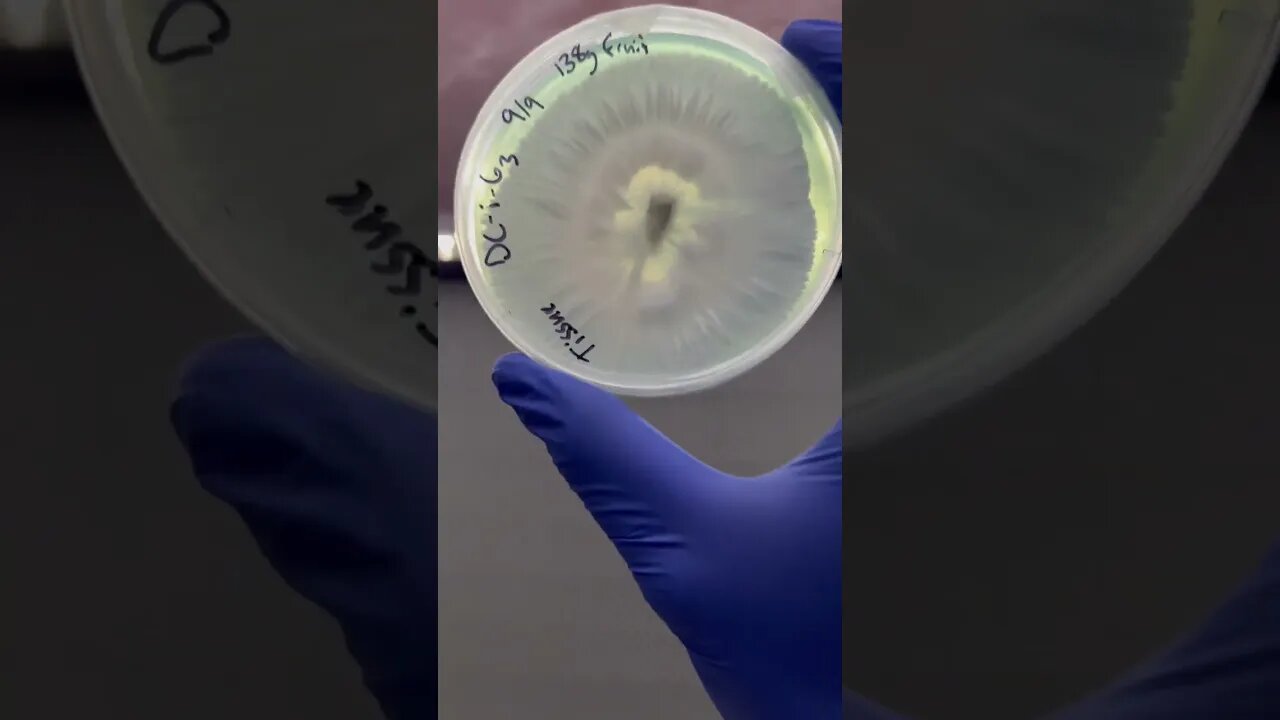
Can’t help Fallin in love all over again

Premium Only Content
This video is only available to Rumble Premium subscribers. Subscribe to
enjoy exclusive content and ad-free viewing.
Can’t help Fallin in love all over again
Loading comments...
-
 LIVE
LIVE
StoneMountain64
41 minutes agoArc Raiders will dominate 2026
49 watching -
 1:18:04
1:18:04
The Shannon Joy Show
2 hours ago🔥SJ LIVE Dec 26 - The Best Of The SJ Show 2025! Epstein, Techno-Fascism & The Military Police State - Will Liberty Prevail? Critical Conversation With Ryan Cristián🔥
11.1K -
 1:09:00
1:09:00
Film Threat
15 hours agoANACONDA! MARTY SUPREME! CHRISTMAS DAY RELEASES REVIEWED! | Film Threat Livecast
11.9K -
 1:00:10
1:00:10
Trumpet Daily
2 hours ago $1.45 earnedTrumpet Daily | Dec. 26, 2025
7.87K2 -
 1:47:33
1:47:33
Badlands Media
13 hours agoBadlands Daily: 12/26/25 – Ongoing Developments, Strategy, and Media Accountability
128K11 -
 2:59:51
2:59:51
Wendy Bell Radio
8 hours agoClean It ALL Up, Mr. President
117K120 -
 8:36
8:36
Buddy Brown
3 hours ago $2.92 earnedBuddy Brown Journaled For 1 YEAR & God SHOCKED Him With His Own Words!
22.9K3 -
 LIVE
LIVE
GloryJean
3 hours agoBirthday Boy Getting some GOOP
59 watching -
 1:11:59
1:11:59
The Big Mig™
4 hours agoHollywood Superstar Isaiah Washington Mar-A-Lago Insiders Edition
14.1K8 -
 LIVE
LIVE
Amish Zaku
4 hours agoRaiders of the Lost Arc
30 watching